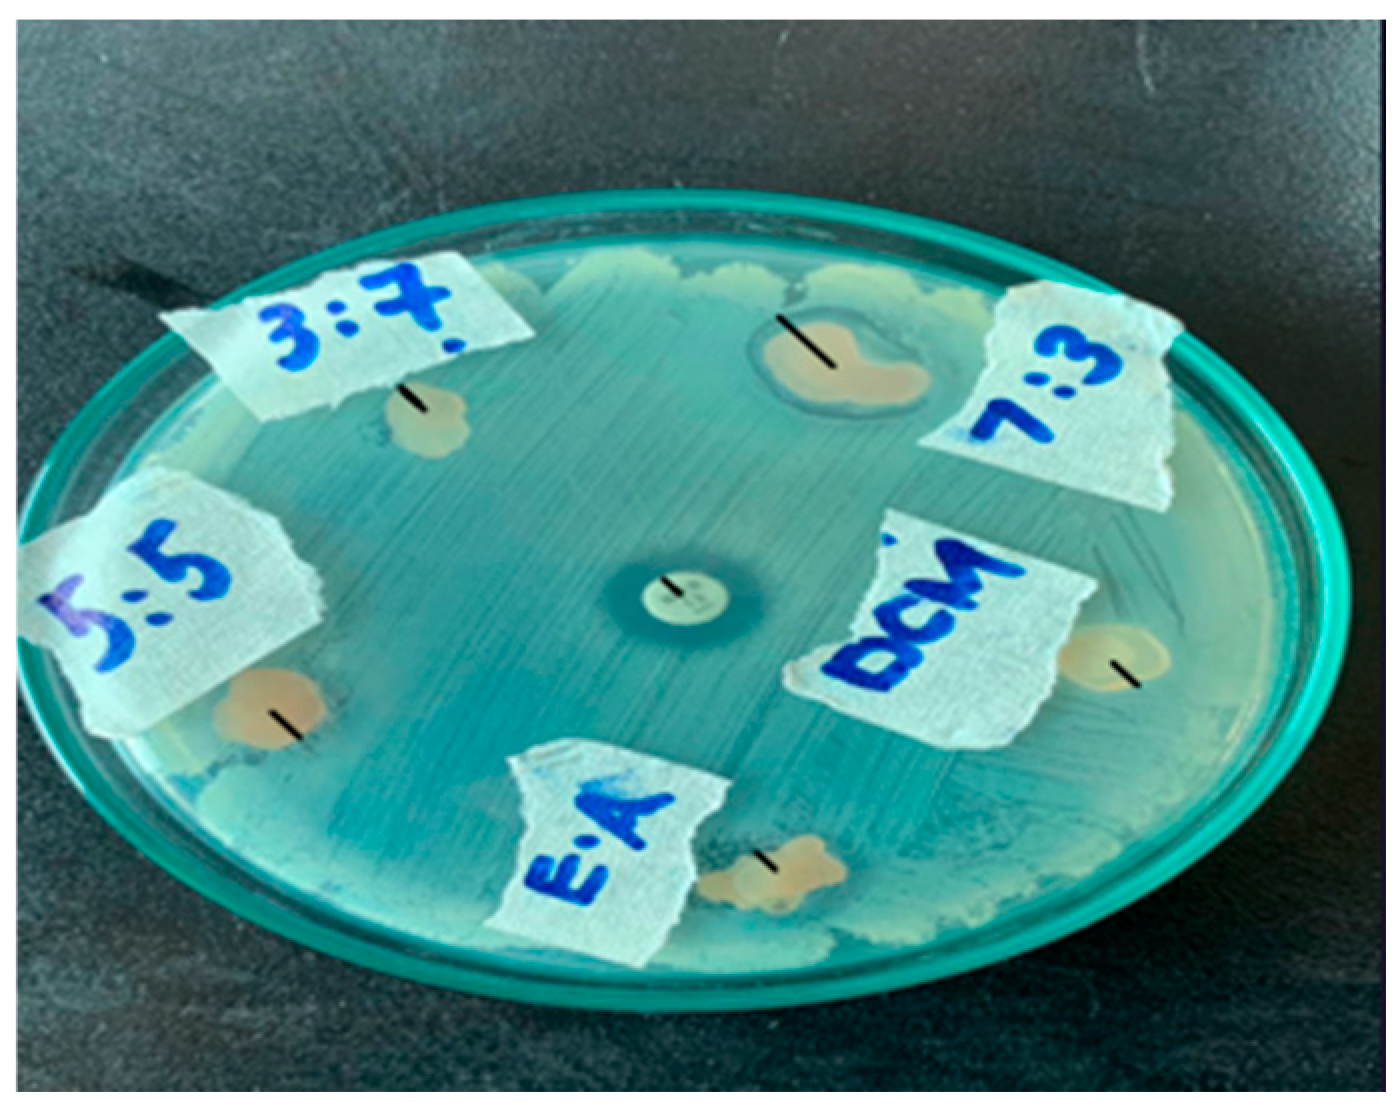
Materproc 23 00015 g003

Polysaccharide-Based Composite Material for Improved Food Packaging †
Abstract
1. Introduction
2. Materials and Methods
Methodology
3. Results and Discussion
3.1. The Phytochemical Analysis
3.2. Antibacterial Activity
3.3. Biodegradability
3.4. Fourier Transform Infrared Spectroscopy
4. Conclusions
Author Contributions
Funding
Institutional Review Board Statement
Informed Consent Statement
Data Availability Statement
Conflicts of Interest
References
- Akhrib, S.; Djellali, S.; Haddaoui, N.; Karimian, D.; Carraro, M. Biocomposites and poly (lactic acid) in active packaging: A review of current research and future directions. Polymers 2024, 17, 3. [Google Scholar] [CrossRef] [PubMed]
- Xie, D.; Ma, H.; Xie, Q.; Guo, J.; Liu, G.; Zhang, B.; Li, X.; Zhang, Q.; Cao, Q.; Li, X. Developing active and intelligent biodegradable packaging from food waste and byproducts: A review of sources, properties, film production methods, and their application in food preservation. Compr. Rev. Food Sci. Food Saf. 2024, 23, e13334. [Google Scholar] [CrossRef] [PubMed]
- Pei, J.; Palanisamy, C.P.; Srinivasan, G.P.; Panagal, M.; Kumar, S.S.D.; Mironescu, M. A comprehensive review on starch-based sustainable edible films loaded with bioactive components for food packaging. Int. J. Biol. Macromol. 2024, 274, 133332. [Google Scholar] [CrossRef] [PubMed]
- Wang, Y.; Liu, K.; Zhang, M.; Xu, T.; Du, H.; Pang, B.; Si, C. Sustainable polysaccharide-based materials for intelligent packaging. Carbohydr. Polym. 2023, 313, 120851. [Google Scholar] [CrossRef] [PubMed]
- Kan, M.; Miller, S.A. Environmental impacts of plastic packaging of food products. Resour. Conserv. Recycl. 2022, 180, 106156. [Google Scholar] [CrossRef]
- Arman Alim, A.A.; Mohammad Shirajuddin, S.S.; Anuar, F.H. A review of nonbiodegradable and biodegradable composites for food packaging application. J. Chem. 2022, 2022, 7670819. [Google Scholar] [CrossRef]
- Wang, Q.; Chen, W.; Zhu, W.; McClements, D.J.; Liu, X.; Liu, F. A review of multilayer and composite films and coatings for active biodegradable packaging. NPJ Sci. Food 2022, 6, 18. [Google Scholar] [CrossRef] [PubMed]
- Janik, W.; Jakubski, Ł.; Kudła, S.; Dudek, G. Modified polysaccharides for food packaging applications: A review. Int. J. Biol. Macromol. 2024, 258, 128916. [Google Scholar] [CrossRef] [PubMed]
- Harbone, J. Experimental Methods in Analytical Chemistry; Chapman and Hall: New York, NY, USA, 1973; pp. 140–145. [Google Scholar]
- Maheshwaran, L.; Nadarajah, L.; Senadeera, S.; Ranaweera, C.; Chandana, A.; Pathirana, R. Phytochemical Testing Methodologies and Principles for Preliminary Screening/Qualitative Testing. Asian Plant Res. J. 2024, 12, 11–38. [Google Scholar] [CrossRef]
- Dilucia, F.; Lacivita, V.; Conte, A.; Del Nobile, M.A. Sustainable use of fruit and vegetable by-products to enhance food packaging performance. Foods 2020, 9, 857. [Google Scholar] [CrossRef] [PubMed]
- Siracusa, V.; Rocculi, P.; Romani, S.; Dalla Rosa, M. Biodegradable polymers for food packaging: A review. Trends Food Sci. Technol. 2008, 19, 634–643. [Google Scholar] [CrossRef]

| Composition | 7:3 Membrane | 5:5 Membrane | 3:7 Membrane | Dichloromethane Membrane | n-Hexane Membrane | Ethyl Acetate Membrane |
|---|---|---|---|---|---|---|
| Starch | 1.5 | 1.5 g | 1.5 g | 1.5 g | 1.5 g | 1.5 g |
| Cyclodextrin | 1.25 | 1.25 g | 1.25 g | 1.25 g | 1.25 g | 1.25 g |
| Alginate | 1.3 | 1.3 g | 1.3 g | 1.3 g | 1.3 g | 1.3 g |
| 20 mL Aqueous Solution of Crude Extract | 14 mL extract + 6 mL water (7:3) | 10 mL extract + 10 mL water (5:5) | 6 mL extract + 14 mL water (3:7) | 14 mL extract + 6 mL DCM | 14 mL extract + 6 mL n-hexane | 14 mL extract + 6 mL ethyl acetate |
| Acetone | 10 mL | 10 mL | 10 mL | 10 mL | 10 mL | 10 mL |
| PVA Solution | 3 mL | 3 mL | 3 mL | 3 mL | 3 mL | 3 mL |
| CaCl2 | 4 mL | 4 mL | 4 mL | 4 mL | 4 mL | 4 mL |
| Serial No | Phytochemical | Result |
|---|---|---|
| 1 | Saponins | Formation of froth indicates the presence of Saponins |
| 2 | Tannins | Appearance of dark green color indicates the presence of Tannins |
| 3 | Flavonoids | Strong yellow color disappeared after the addition of HCl, indicating the presence of flavonoids |
| 4 | Terpenoids | Appearance of reddish brown color at the interface, indicating the presence of terpenoids |
| 5 | Carotenoids | Appearance of blue-green color at the end confirmed the presence of carotenoids |
| 6 | Phenols | Appearance of blue green color at the end confirmed the presence of phenols |
Disclaimer/Publisher’s Note: The statements, opinions and data contained in all publications are solely those of the individual author(s) and contributor(s) and not of MDPI and/or the editor(s). MDPI and/or the editor(s) disclaim responsibility for any injury to people or property resulting from any ideas, methods, instructions or products referred to in the content. |
© 2025 by the authors. Licensee MDPI, Basel, Switzerland. This article is an open access article distributed under the terms and conditions of the Creative Commons Attribution (CC BY) license (https://creativecommons.org/licenses/by/4.0/).
Share and Cite
Khan, K.A.; Khan, K.; Lakhesar, M.H.; Waqas, M.; Ahmed, T.; Jafry, A.T.; Yaqub, A.; Ajab, H.; Khan, S.A. Polysaccharide-Based Composite Material for Improved Food Packaging. Mater. Proc. 2025, 23, 15. https://doi.org/10.3390/materproc2025023015
Khan KA, Khan K, Lakhesar MH, Waqas M, Ahmed T, Jafry AT, Yaqub A, Ajab H, Khan SA. Polysaccharide-Based Composite Material for Improved Food Packaging. Materials Proceedings. 2025; 23(1):15. https://doi.org/10.3390/materproc2025023015
Chicago/Turabian StyleKhan, Khushbakht Ali, Khudija Khan, Muhammad Hassan Lakhesar, Muhammad Waqas, Tauseef Ahmed, Ali Turab Jafry, Asim Yaqub, Huma Ajab, and Shahid Ali Khan. 2025. "Polysaccharide-Based Composite Material for Improved Food Packaging" Materials Proceedings 23, no. 1: 15. https://doi.org/10.3390/materproc2025023015
APA StyleKhan, K. A., Khan, K., Lakhesar, M. H., Waqas, M., Ahmed, T., Jafry, A. T., Yaqub, A., Ajab, H., & Khan, S. A. (2025). Polysaccharide-Based Composite Material for Improved Food Packaging. Materials Proceedings, 23(1), 15. https://doi.org/10.3390/materproc2025023015
